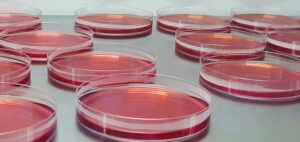

Details on Different Sizes of Cell Culture Dishes and Flasks
Cell culture dishes and flasks come in various sizes. Below are some useful numbers such as surface area, seeding density, and volumes of media & reagent solutions for different culture vessels:

| Culture plate | Surface Area (cm²) | Seeding Density | Cells at Confluency | Trypsin 0.05% trypsin (mL) | Growth Medium (mL) |
|---|---|---|---|---|---|
| 35mm Dish | 8.8 | 0.3 x 10⁶ | 1.2 x 10⁶ | 1 | 2 |
| 60mm Dish | 21.5 | 0.8 x 10⁶ | 3.2 x 10⁶ | 3 | 5 |
| 100mm Dish | 56.7 | 2.2 x 10⁶ | 8.8 x 10⁶ | 5 | 12 |
| 150mm Dish | 145 | 5.0 x 10⁶ | 20.0 x 10⁶ | 10 | 30 |
| 6-well Plate | 9.6 | 0.3 x 10⁶ | 1.2 x 10⁶ | 1 | 1–3 |
| 12-well Plate | 3.5 | 0.1 x 10⁶ | 0.5 x 10⁶ | 0.4–1 | 1–2 |
| 24-well Plate | 1.9 | 0.05 x 10⁶ | 0.24 x 10⁶ | 0.2–0.3 | 0.5–1.0 |
| 48-well Plate | 1.1 | 0.03 x 10⁶ | 0.12 x 10⁶ | 0.1–0.2 | 0.2–0.4 |
| 96-well Plate | 0.32 | 0.01 x 10⁶ | 0.04 x 10⁶ | 0.05–0.1 | 0.1–0.2 |
| 384-well Plate | 0.084 | 0.0018 x 10⁶ | 0.0072 x 10⁶ | 0.015 | 0.08 |
| T-25 Flask | 25 | 0.7 x 10⁶ | 2.8 x 10⁶ | 3 | 3–5 |
| T-75 Flask | 75 | 2.1 x 10⁶ | 8.4 x 10⁶ | 5 | 10–15 |
